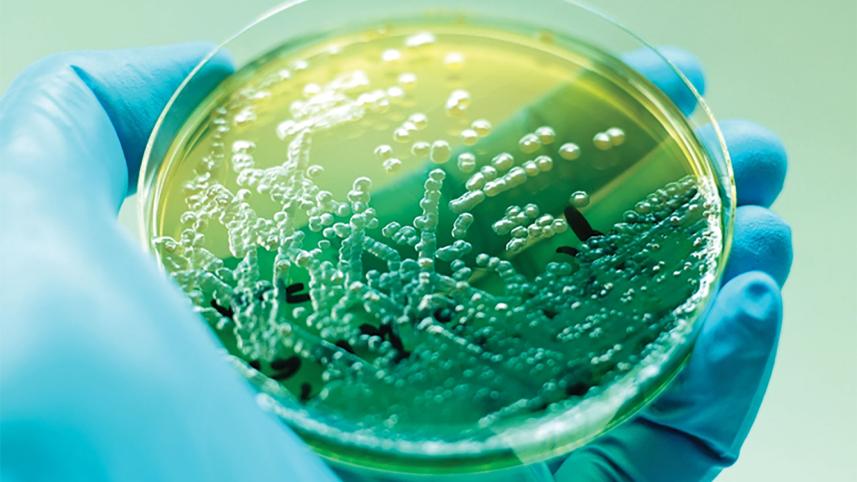
common-bacterial-infections.jpg

The burden of bacterial infections, the second leading cause of death globally
Common bacterial infections were the second leading cause of death in 2019, and were linked to one in eight deaths globally, according to an analysis published in The Lancet.
There were 7.7 million deaths in 2019 associated with 33 common bacterial infections, with five bacteria alone connected to more than half of all deaths. The deadliest bacterial pathogens and types of infection varied by location and age.
Second only to ischaemic heart disease as the leading cause of death in 2019, the analysis highlights reducing bacterial infections as a global public health priority. Building stronger health systems with greater diagnostic laboratory capacity, implementing control measures, and optimising antibiotic use is crucial to lessen the burden of disease caused by common bacterial infections.
While many estimates exist for pathogens such as tuberculosis, malaria, and HIV, until now estimates of the disease burden of bacterial pathogens were limited to a handful of specific pathogens and types of infection, or focused only on specific populations. More deaths were linked to two of the deadliest pathogens – S. aureus and E. coli – than HIV/AIDS (864,000 deaths) in 2019, yet analysis shows HIV research was awarded $42 billion dollars while E. coli research was awarded $800 million. The authors say such funding gaps might have arisen because there was, until now, a lack of data on the global burden of these infections.
The new study provides the first global estimates of mortality associated with 33 common bacterial pathogens and 11 major infection types – known as infectious syndromes – leading to death from sepsis. Estimates were produced for all ages and sexes across 204 countries and territories. Utilising data and methods from the Global Burden of Disease 2019 and Global Research on Antimicrobial Resistance (GRAM) studies, the authors used 343 million individual records and pathogen isolates to estimate deaths associated with each pathogen and the type of infection responsible.



 For all latest news, follow The Daily Star's Google News channel.
For all latest news, follow The Daily Star's Google News channel.
Comments